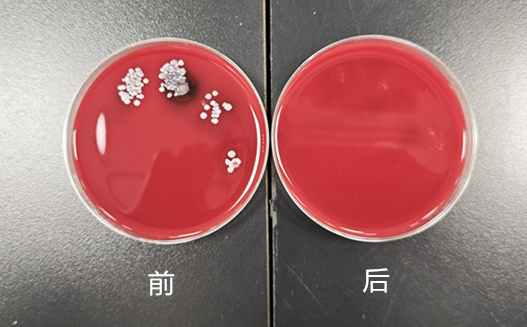
洗手前后对比.jpg

教学动态
儿科临床医学院开展本学期《临床思维早训练》教学
为强化儿科学生的临床实践能力,培养兼具医学人文和良好职业素养的卓越儿科医师,儿科临床医学院面向2024级儿科“5+3”学生精心设计并完成了本学期两期“走进医院”主题活动。通过情景模拟演练与技能实操相结合的方式,帮助大一学生提前建立临床思维,夯实基本功。
5月7日,在园区儿童医院的三间教室里,由凌婧、吴水燕、孔令军三位“5+3”临床导师指导学生分别扮演医生、护士、家属等角色,聚焦《儿童发热与抽搐急诊流程》,完整演练了急诊接诊、评估与处置流程。每组演练结束后,临床导师引导学生针对“如何快速识别危重症”“如何优化处置顺序”等核心问题进行复盘。这种沉浸式学习让学生提前感受到了临床节奏,更加体会到医生工作的使命与担当。



6月4日,在东延四季临床技能中心,朱振洪、张福勇、吴水燕三位“5+3”临床导师围绕“手卫生”和“心肺复苏”开展了技能培训和考核。为了确保教学效果,学院提前向学生发放标准操作视频及评分表,要求学生课前自主学习。培训当天,“手卫生”首次采用了与手术室同规格的设施,学生进行外科洗手前后分别在培养皿上按压手印,两天后,我院检验科将培养48小时的洗手前后的菌落分布图反馈至学生,让学生第一次直观地感受到了医学的严谨性,强化了“无菌观念”的科学认知。“心肺复苏”则借助实时反馈模拟人,实时显示按压深度、频率及回弹数据,帮助学生及时调整操作,增强了学生的成就感。

“早临床、多临床、反复临床是儿科医生培养的关键。”课程负责人黄莉全程参与了两次活动后表示,未来将持续优化课程设计,将更多临床真实场景和量化工具融入教学,帮助学生实现从课堂到临床的转变,为今后成长为一名卓越儿科医师打下基础。
儿科临床医学院办公室
| Copyright © 苏州大学医学部儿科临床医学院 All rights reseved 主办单位: 苏州大学附属儿童医院儿科学系 苏ICP备032925 医药卫生信息服务许可证:苏卫网审字第03-1号 |
